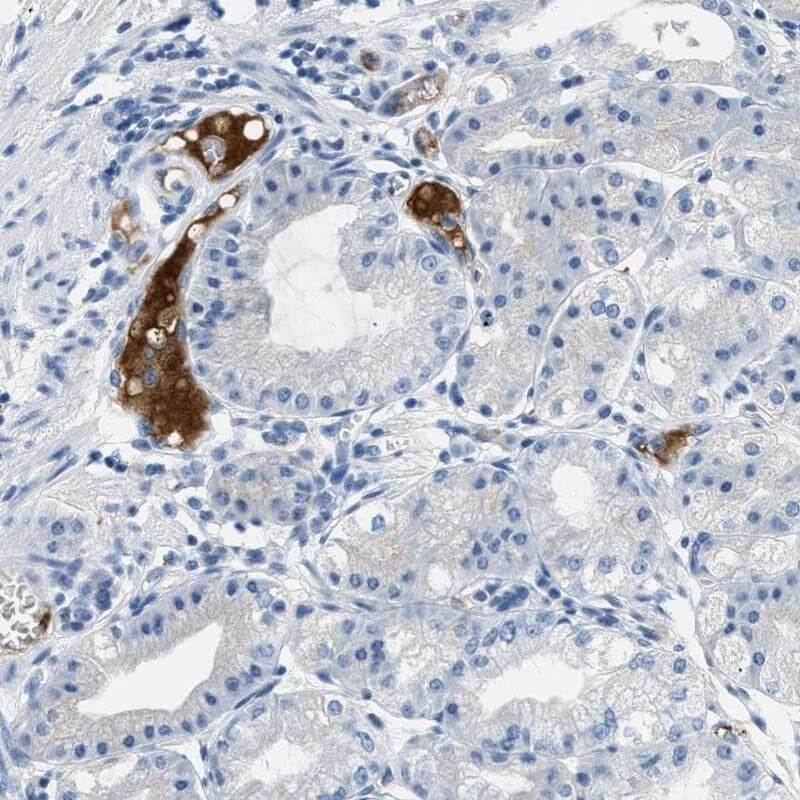
IHC stomach analysis. (Creative Biolabs Original)

Anti-A2M Recombinant Antibody Products
 Loading...
Loading...Anti-A2M Products
 Loading...
Loading...- Rabbit Anti-A2M Recombinant Antibody (clone JM81-41) (MRO-0015-CN)
-
- Species Reactivity: Human
- Type: Rabbit IgG
- Application: WB, IHC
- Mouse Anti-A2M Recombinant Antibody (clone 3-G5) (MRO-0078-CN)
-
- Species Reactivity: Human
- Type: Mouse IgG2c
- Application: WB, IHC, ELISA
- Mouse Anti-A2M Recombinant Antibody (clone A5-A9) (MRO-0079-CN)
-
- Species Reactivity: Human
- Type: Mouse IgG1
- Application: WB, IHC, ELISA
- Mouse Anti-A2M Recombinant Antibody (clone 8-B10) (MRO-0080-CN)
-
- Species Reactivity: Human
- Type: Mouse IgG1
- Application: WB, IHC, ELISA
- Mouse Anti-A2M Recombinant Antibody (clone B1-D7) (MRO-0081-CN)
-
- Species Reactivity: Human
- Type: Mouse IgG1
- Application: WB, IHC, ELISA
- Mouse Anti-A2M Recombinant Antibody (clone A10-A9) (MRO-0082-CN)
-
- Species Reactivity: Human
- Type: Mouse IgG1
- Application: WB, IHC, ELISA
- Mouse Anti-A2M Recombinant Antibody (clone 2-F4) (MRO-0083-CN)
-
- Species Reactivity: Human
- Type: Mouse IgG2a
- Application: WB, IHC, ELISA
- Mouse Anti-A2M Recombinant Antibody (clone 3E0) (MOB-0589MZ)
-
- Species Reactivity: Human
- Type: Mouse IgG1
- Application: ELISA, IHC-P, WB
- Mouse Anti-A2M Recombinant Antibody (clone 6-E4) (MRO-0084-CN)
-
- Species Reactivity: Human
- Type: Mouse IgG2b
- Application: WB, IHC, ELISA
- Chicken Anti-A2M Polyclonal IgY (BRD-0890MZ)
-
- Species Reactivity: Human, Mouse, Rat
- Type: Chicken antibody
- Application: ELISA, WB
-
- Derivation: Phage display library screening
- Species Reactivity: Human
- Type: Rabbit IgG
- Application: IHC-P, WB
- Anti-A2M Immunohistochemistry Kit (VS-0325-XY1)
-
- Species Reactivity: Human
- Target: A2M
- Application: IHC
- Anti-Mouse A2M Immunohistochemistry Kit (VS-0525-XY1)
-
- Species Reactivity: Human, Mouse, Rat
- Target: A2M
- Application: IHC
Can't find the products you're looking for? Try to filter in the left sidebar.Filter By Tag
Our customer service representatives are available 24 hours a day, from Monday to Sunday. Contact Us
For Research Use Only. Not For Clinical Use.
Are prolonged drug development cycles and inconsistent antibody performance hindering your research on inflammatory or neurodegenerative diseases? Creative Biolabs' Anti-A2M Recombinant Antibodies leverage cutting-edge mammalian expression systems and rigorous functional validation to deliver unparalleled specificity and batch-to-batch reproducibility. Designed for demanding applications like biomarker quantification, protein interaction studies, and therapeutic target validation, these antibodies empower researchers to overcome variability challenges and accelerate translational discoveries.
A2M: A Multifaceted Regulator of Proteolytic Cascades
Creative Biolabs' recombinant antibodies against A2M are engineered to recognize distinct conformational epitopes critical for studying its protease-trapping mechanism. With high affinity and minimal cross-reactivity, these tools enable precise detection of A2M in complex biological matrices, including serum, cerebrospinal fluid, and tumor microenvironment samples.
Alternative Names
α2M; CPAMD5; S863-7; C3 and PZP-like alpha-2-macroglobulin domain-containing protein 5.
Background
The protein encoded by this gene is a protease inhibitor and cytokine transporter. It uses a bait-and-trap mechanism to inhibit a broad spectrum of proteases, including trypsin, thrombin and collagenase. It can also inhibit inflammatory cytokines, and it thus disrupts inflammatory cascades. Mutations in this gene are a cause of alpha-2-macroglobulin deficiency. This gene is implicated in Alzheimer's disease (AD) due to its ability to mediate the clearance and degradation of A-beta, the major component of beta-amyloid deposits. A related pseudogene, which is also located on the p arm of chromosome 12, has been identified.
Cancer-related genes, Candidate cardiovascular disease genes, Plasma proteins
Secreted
Cell type enhanced (Adipocytes, Hepatocytes, Endothelial cells, Horizontal cells, Hepatic stellate cells)
Immune cell enhanced (gdT-cell)
Group enriched (AF22, ASC diff, Hep G2, SK-MEL-30)
Homotetramer; disulfide-linked.
Protease inhibitor, Serine protease inhibitor
Anti-A2M rAb Products
Creative Biolabs' antibody catalog features formats optimized for ELISA, Western blot, immunohistochemistry (IHC), and flow cytometry, with species reactivity spanning human, murine, and primate models. Designed to minimize lot-to-lot variability, these reagents guarantee consistency throughout longitudinal studies.
| Cat. No. | Product Name | Target Species | Host Species | Applications |
| MRO-0015-CN | Rabbit Anti-A2M Recombinant Antibody (clone JM81-41) | Human | Rabbit IgG | WB, IHC |
| MRO-0078-CN | Mouse Anti-A2M Recombinant Antibody (clone 3-G5) | Human | Mouse | WB, IHC, ELISA |
| BRD-0890MZ | Chicken Anti-A2M Polyclonal IgY | Human, Mouse, Rat | Chicken | ELISA, WB |
| MOR-0002 | Hi-Affi™ Rabbit Anti-A2M Recombinant Antibody (clone DS2AB) | Human | Rabbit | IHC-P, WB |
Table.1 Featured anti-A2M recombinant antibody products at Creative Biolabs.
Creative Quality Control
Creative Biolabs applies stringent quality control measures to all anti-A2M recombinant antibody products, with each batch thoroughly validated for specificity, sensitivity, and functional performance. This rigorous process ensures that our antibodies consistently meet the highest industry standards, delivering reliable and high-performing reagents for even the most challenging applications.
 Fig.1 IHC staining of human liver.
Fig.1 IHC staining of human liver.
(Cat# MRO-0015-CN, Creative Biolabs).
Fig.2 IHC analysis of anti-A2M antibody.
Fig.2 IHC analysis of anti-A2M antibody.
(Cat# MRO-0015-CN, Creative Biolabs).
 Fig.3 Colon IHC staining of anti-A2M antibody.
Fig.3 Colon IHC staining of anti-A2M antibody.
(Cat# MRO-0015-CN, Creative Biolabs).
 Fig.4 Liver IHC staining of anti-A2M antibody.
Fig.4 Liver IHC staining of anti-A2M antibody.
(Cat# MOR-0002, Creative Biolabs).
Customer Reviews

Rabbit Anti-A2M Recombinant Antibody (clone R03-5A4)

Mouse Anti-A2M Recombinant Antibody (clone 3-G5)

Rabbit Anti-A2M Recombinant Antibody (clone R03-5A4)
rAb Production
Our mammalian system, devoid of serum, guarantees both the precision of post-translational modifications and the ability to scale production from milligrams to grams. By incorporating AI-powered codon optimization alongside perfusion bioreactor advancements, we attain monomeric purity exceeding 95%, essential for crucial in vivo and diagnostic uses.
Featured Anti-A2M Recombinant Antibody Production Platforms
Fig.5 Production of recombinant anti-A2M antibodies on a milligram scale.
 Fig.6 Synthesis of recombinant anti-A2M antibodies at gram-scale quantities.
Fig.6 Synthesis of recombinant anti-A2M antibodies at gram-scale quantities.
rAb Modalities
From bispecific formats blocking A2M-protease interactions to Fc-engineered variants enhancing tissue penetration, Creative Biolabs offers customizable solutions. Delve into antibody fragments such as Fab and scFv, various IgG subclasses, and conjugated derivatives, all customized to fit your experimental requirements.
 Fig.7 Full-length anti-A2M recombinant antibody production and modalities.
Fig.7 Full-length anti-A2M recombinant antibody production and modalities.
Creative Biolabs is dedicated to advancing your research with superior anti-A2M recombinant antibody offerings. Our pursuit of scientific excellence and commitment to client satisfaction drive us to deliver innovative solutions. If you are interested in our products or wish to discuss your specific project requirements, please reach out to us. Our team of experts stands prepared to assist you in achieving your research goals.

